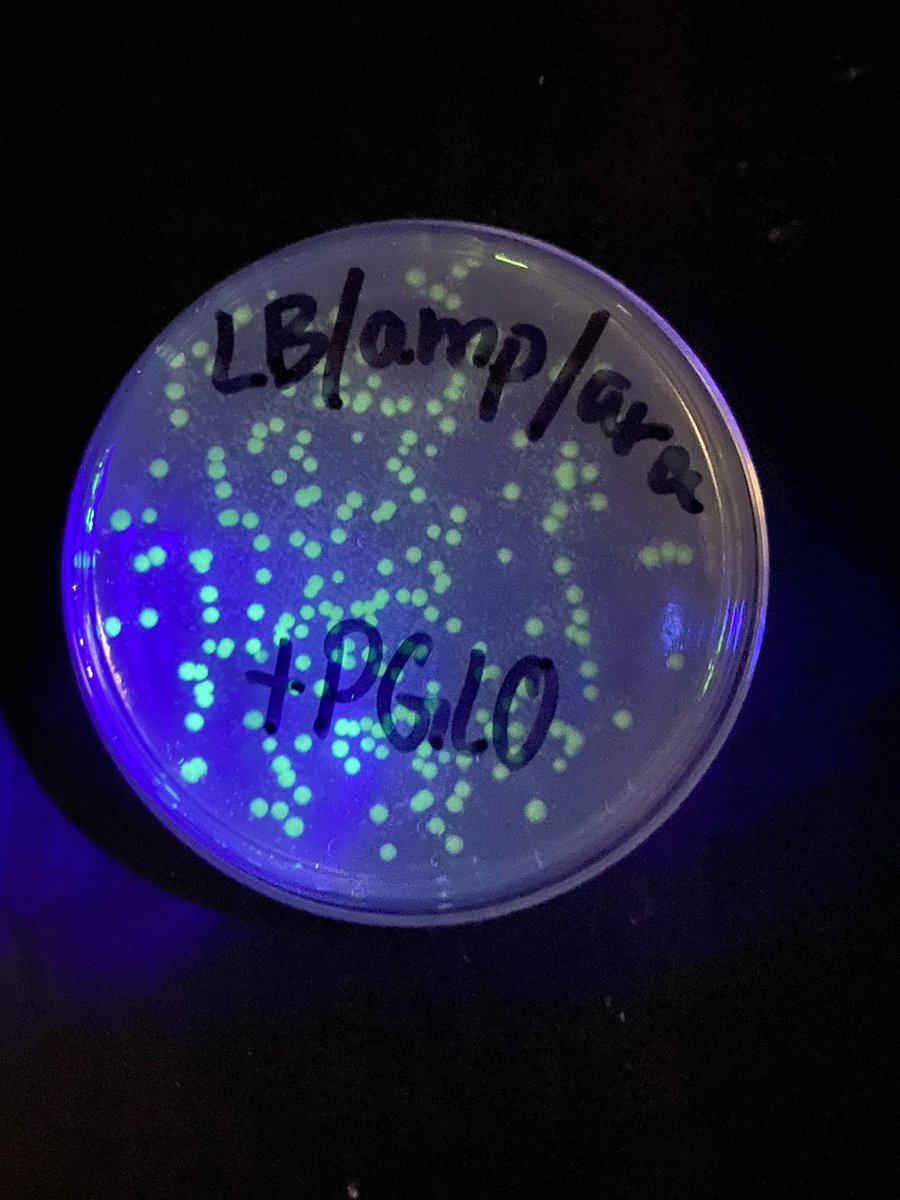
ARobScience's tweet image. Transformation success! I’m very proud of my AP Bio Ss this week. Keep up the hard work wildcats!
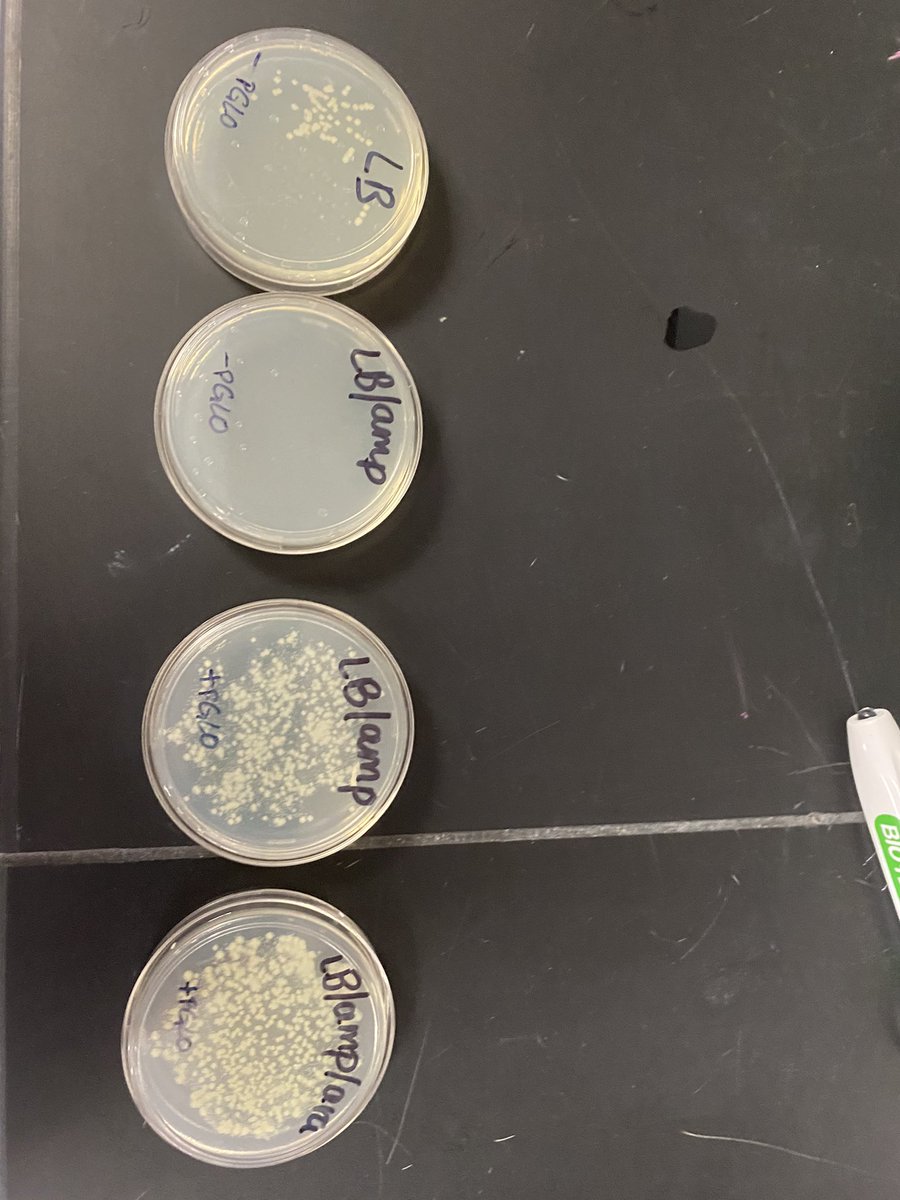
ARobScience's tweet image. 🥼 AP Bio Ss transformed bacteria with two genes- one for ampicillin resistance and another for green fluorescence. Stay tuned tomorrow to see if they glow green!#apbio #microbiology

Andrea Robertson
@ARobScience
Science teacher at Marcus Whitman
قد يعجبك
AP Ss had a blast with the cell membrane bubble lab today.

I am pretty excited about the enthusiasm and energy that these six have for improving our school’s sustainability efforts. #flycs2022 #climateaction #youth4climate #youthclimatesummit



Great day for AP Bio Ss at Taughannock Falls. We calculated Simpson’s biodiversity index in two locations and saw a nice Jack in the Pulpit and some fiddleheads along the way. #MWTweets #PR1DEinthePaw




We are super proud of our Envirothon teams. Our Sr/Jr team of Ben Clovis, Johann Kintzel, William Sloth, Natalie Cunningham, and Austin Kephart placed first in the Wayne- Finger Lakes Regional Envirothon yesterday.


Very proud of our 4 Envirothon teams who competed in the virtual regionals today. Stay tuned for results tomorrow! #Envirothon #MWtweets



Great day around the school grounds today. LE Ss planted 10 white pines for Arbor Day and AP Bio Ss collected isopod for their behavior lab next week. #ArborDay #MWtweets @lahue_jordan




Transformation success! I’m very proud of my AP Bio Ss this week. Keep up the hard work wildcats!
🥼 AP Bio Ss transformed bacteria with two genes- one for ampicillin resistance and another for green fluorescence. Stay tuned tomorrow to see if they glow green!#apbio #microbiology

Operation: Keep the plastic out of the landfill is underway. We collected over 35 pounds today from our friends in 3rd and 4th grades. Keep saving your plastic films for the drive, which ends on 12/15!@AmyDobbertin @GwenWinkler #envirothon #PR1DEinthePaw


Cyclosis in action today. Ss got to view the chloroplasts in full motion as they photosynthesized under our digital light microscopes. #Biology
AP Ss did one of my favorite labs 🥼 today: an investigation to see how surface area:volume affects diffusion.

LE Ss had a great day at MWOC taking measurements of pond depth, productivity, temperature, pH, and DO.

My classroom for today. My Ss took goldenrod hall hunting very seriously! #MWOC #Pr1deinthePaw

It was so great to see members of the Class of 2021 today for painted parking spaces and my Co advisor and pal @AndreaBushMW today. #Classof2021 #PR1DEinthePaw

So proud of these three amazing seniors who endured a tough AP Bio Exam today. Missing our days together!

United States الاتجاهات
- 1. Porzingis N/A
- 2. Kuminga N/A
- 3. Warriors N/A
- 4. Gonzaga N/A
- 5. Skubal N/A
- 6. Podz N/A
- 7. Hield N/A
- 8. Dalen Terry N/A
- 9. #AEWDynamite N/A
- 10. Yabu N/A
- 11. Ty Jerome N/A
- 12. POTS N/A
- 13. #DubNation N/A
- 14. Knicks N/A
- 15. Lobos N/A
- 16. Trey Murphy N/A
- 17. Zags N/A
- 18. Draymond N/A
- 19. Golden State N/A
- 20. Tingus Pingus N/A
Something went wrong.
Something went wrong.

























































































